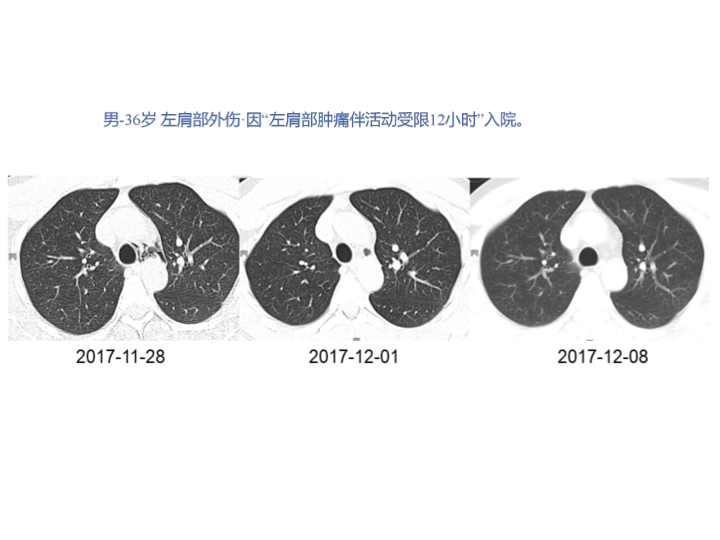

胸部外伤及胸腔积液处理


原创
2025-08-19
作者:王沂
来源:快医精选
阅读量:3

(本网站所有内容,凡注明原创或来源为“快医精选”,版权均归快医精选所有,未经授权,任何媒体、网站或个人不得转载,否则将追究法律责任,授权转载时须注明“来源:快医精选”。本网注明来源为其他媒体的内容为转载,转载仅作观点分享,版权归原作者所有,如有侵犯版权,请及时联系我们。)
 0
0
0 / 150












